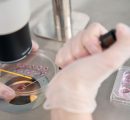

Hp2
Vance contro Kamala Harris e le donne senza figli
Jd Vance potrebbe essere il prossimo vicepresidente degli Stati Uniti, con il ritorno di Donald Trump alla Casa Bianca. Kamala Harris, ormai con buonissime probabilità, è la candidata Democratica che contenderà nei prossimi 105 giorni
Vite spezzate, Napoli teatro di violenza: l’analisi del pedagogista
Emanuele Tufano, Santo Romano e Arcangelo Correra avevano rispettivamente 15, 17 e 18 anni quando la violenza ne ha stroncato le giovani vite. Sono loro le ultime tre vittime di un fenomeno che ha sconvolto
Vitamina D, influisce sulla fertilità?
Un corpo sano è la somma delle giuste abitudini, dello stile di vita e di un’adeguata quantità di nutrienti essenziali nella vita di tutti i giorni e la vitamina D è uno dei fattori a
Vitamina D in inverno, tutto quello che devi sapere
Con l’arrivo dell’inverno, la vitamina D diventa una protagonista silenziosa della nostra salute. Essenziale per il benessere delle ossa, dei muscoli e del sistema immunitario, questa vitamina si riduce proprio nei mesi freddi, quando le
Visco ‘pesa’ il calo demografico: 800mila in meno in età da lavoro in 3 anni
Il calo demografico pesa, e molto, anche sul piano economico, sul mercato del lavoro e, a cascata, sui redditi e il potere d’acquisto. Le aspettative di vita sono più alte, si lavora più a lungo
Virus sinciziale nei neonati, la protezione in Italia dipende dalla regione
Se c’è un momento in cui la fortuna dovrebbe essere uguale per tutti, è sicuramente la nascita. Eppure, per i neonati italiani la protezione dal virus respiratorio sinciziale (Vrs) – una delle principali cause di
Vip italiane spogliate con l’intelligenza artificiale: scoperto nuovo sito di deepnude
Aperto da 11 anni, con 7 milioni di utenti il tutto il mondo, ha rappresentato l’ennesimo abuso sul corpo delle donne. Parliamo di SocialMediaGirls, l’ultima piattaforma sessista scoperta in Italia grazie alla denuncia della giornalista
Violenza, il 29% degli adolescenti pensa che una ragazza contribuisca a provocarla
Per il 43% degli adolescenti, se davvero una ragazza non vuole avere un rapporto sessuale, il modo di sottrarsi lo può trovare. Il 29% degli adolescenti intervistati, inoltre, ritiene che le ragazze possano contribuire a
Violenza sulle donne, se ne parla di più e ci si vergogna di meno
Gli stereotipi di genere e l’immagine sociale della violenza sono i temi al centro dell’indagine odierna dell’Istituto nazionale di statistica. I dati forniti dall’Istat (dati provvisori maggio-luglio 2023) offrono uno sguardo interessante sulla percezione della
Violenza sulle donne, +57% di chiamate al 1522 nel 2024. La società sta cambiando?
Da gennaio a settembre 2024, le chiamate al 1522 sono aumentate del 57% rispetto allo stesso periodo del 2023 per un totale di 48.000 chiamate. Il dato dimostra come il numero anti violenza e stalking
Violenza sui minori: l’87% dei casi avviene in famiglia
Tredici minorenni italiani ogni mille sono vittime di maltrattamento. Il maltrattamento colpisce indistintamente maschi e femmine. Nell’87% dei casi il maltrattante appartiene alla cerchia familiare ristretta. Questa è la fotografia emersa dalla III Indagine nazionale
‘Broligarchia’: cos’è e perché minaccia la democrazia
Elon Musk, Mark Zuckerberg, Jeff Bezos, Sam Altman, Sundar Pichai, Tim Cook. Nel giorno del giuramento di Donald Trump come
‘Cyber-Gesù’ ti ascolta, l’intelligenza artificiale arriva nel confessionale: miracolo tech o esperimento eretico?
In principio era il Verbo. Ora è un algoritmo. Se pensavate che la spiritualità fosse l’ultimo baluardo immune dall’invasione tecnologica,
‘Donne, lavoro e sfide demografiche’, lo studio di Fondazione Gi Group e Valore D
Occupazione femminile e natalità, due facce della stessa medaglia. Ne è convinta Chiara Violini, presidente della Fondazione Gi Group che